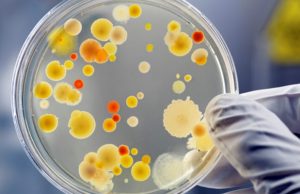
Ротавірусна інфекція: симптоми та профілактика Ротавірусна-інфекція:-симптоми-та-профілактика

novrada
У Нововолинську обговорили заходи з профілактики девіантної поведінки серед дітей
Джерело: Нововолинська міська рада
У четвер, 6 лютого, відбулася робоча зустріч освітян, психологів, соціальних педагогів, представників поліції, центру соціальних служб і служби у справах дітей....
Нововолинська громада попрощалася із Захисником України
Джерело: Нововолинська міська рада
У п’ятницю, 7 лютого, Нововолинська громада провела в останню путь Героя — Дмитра Аршуліка, який віддав життя, захищаючи Україну.
До Свято-Духівського...
До уваги внутрішньо переміщених осіб з інвалідністю
Джерело: Нововолинська міська рада
Якщо під час отримання допомоги на проживання внутрішньо переміщеним особам (далі – Допомога) настав строк повторного огляду медико-соціальною експертною комісією...
«Укрпошта» запрошує на роботу листоношу
Джерело: Нововолинська міська рада
«Укрпошта» – національний оператор поштового зв’язку, надійний та відповідальний роботодавець.
Сьогодні команда «Укрпошти» – це фахівці, які руйнують стереотипи, щоденно працюють...
Міський голова провів прийом громадян у Нововолинську
Джерело: Нововолинська міська рада
У середу, 5 лютого, міський голова Борис Карпус провів прийом громадян у Нововолинську. Під час якого поспілкувався з 40 мешканцями громади,...
Відбулося засідання комісії з встановлення факту здійснення догляду
Джерело: Нововолинська міська рада
У вівторок, 4 лютого, під головуванням заступниці міського голови Ніни Шумської відбулося чергове засідання комісії з встановлення факту здійснення особою догляду...
Оголошено прийом заявок на Національний конкурс «Благодійна Україна-2024»
Джерело: Нововолинська міська рада
Національний конкурс «Благодійна Україна» – щорічний всеукраїнський конкурс з відзначення найкращих благодійників і найбільш ефективних благодійних та волонтерських ініціатив в Україні. Конкурс...
Про хід виконання бюджету Нововолинської міської територіальної громади станом на 01.02.2025...
Джерело: Нововолинська міська рада
04.02.2025/в Новини міста /Фінансове управління виконавчого комітету повідомляє, що обсяг бюджету Нововолинської міської територіальної громади за доходами станом на 01.02.2025 року...
Актуальна інформація щодо епідситуації на грип, ГРВІ та COVID-19 у Нововолинській...
Джерело: Нововолинська міська рада
За даними епіднагляду за 5-й тиждень з 27 січня по 02 лютого на гострі респіраторні вірусні інфекції захворіло 175 осіб, що...
Представники Нововолинської громади взяли участь у всеукраїнському семінарі щодо раннього втручання
Джерело: Нововолинська міська рада
31 січня у Львові відбувся всеукраїнський семінар з раннього втручання, який об’єднав 36 команд з різних регіонів.
Нововолинськ представили заступниця міського...
У терцентру соціального обслуговування – нова керівниця
Джерело: Нововолинська міська рада
У понеділок, 3 лютого, міський голова Борис Карпус представив колективу територіального центру соціального обслуговування нову директорку. Нею стала Вікторія Павленко.
Пані...
Вшановуємо пам’ять Героїв, які загинули в лютому
Джерело: Нововолинська міська рада
Одинадцять років тому під час Революції Гідності загинув Герой Сергій Байдовський.
Пʼять років минає, як нестало Захисника Артура Зектера.
Треті роковини...
Продаж земельних ділянок у Благодатному та Низкиничах Нововолинської громади: запрошуємо покупців...
Джерело: Нововолинська міська рада
Продається земельна ділянка несільськогосподарського призначення у Благодатному біля траси Т0305.
Площа: 0,5 га.
Кадастровий номер: 0710745300:06:035:0001.
Категорія земель – землі...
З лютого 2025 року відкривається прийом заявок у Державному аграрному реєстрі
Джерело: Нововолинська міська рада
Відповідно до постанови Кабінету Міністрів України від 16.08.2022 №918 (зі змінами) з 3 лютого 2025 року розпочнеться прийом заявок у...
Ротавірусна інфекція: симптоми та профілактика
Джерело: Нововолинська міська рада
Ротавірусна інфекція – гостре кишкове захворювання з проявами інтоксикації. Широко розповсюджене у всьому світі. Хвороба дуже заразна, захворіти можна після потрапляння...
Розпочато реалізацію проєкту з розробки техніко-економічного обґрунтування модернізації очисних споруд Нововолинська
Джерело: Нововолинська міська рада
У середу, 29 січня, відбулася перша зустріч у форматі онлайн/офлайн-конференції щодо запуску проєкту «Техніко-економічне обґрунтування модернізації каналізаційної очисної станції м. Нововолинськ...
Поновлено позапланові перевірки у сфері надання житлово-комунальних послуг
Джерело: Нововолинська міська рада
Відповідно до постанови Кабінету Міністрів України від 13.03.2022 № 303 Держпродспоживслужба може здійснювати позапланові заходи державного нагляду (контролю) за дотриманням суб’єктами...
Як Національна служба здоров’я України оплачує амбулаторні послуги в 2025 році?
Джерело: Нововолинська міська рада
У 2025 році НСЗУ деталізувала перелік безоплатних послуг для пацієнта в амбулаторних умовах. Тож цьогоріч за пакетом «Профілактика, діагностика, спостереження...
ПРОТОКОЛ №4 засідання виконавчого комітету від 28 січня 2025 року
Джерело: Нововолинська міська рада
Виконавчий комітет Нововолинської міської ради
ВОЛИНСЬКОЇ ОБЛАСТІ
ПРОТОКОЛ
28 січня 2025 року м. Нововолинськ №4
...
Інформація про результат продажу об’єкта комунальної власності Нововолинської територіальної громади
Джерело: Нововолинська міська рада
Результати продажу об’єкта малої приватизації – нежитлового приміщення загальною площею 88,2 м2, що знаходиться за адресою: вулиця Нововолинська, будинок №...